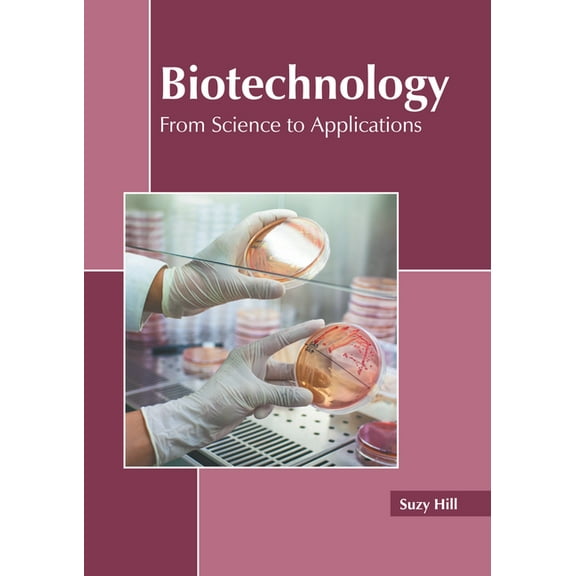
Biotechnology: From Science to Applications, (Hardcover)

Fractal Analysis: Applications in Health Sciences and Social Sciences (Hardcover)
(No ratings yet)
Current price is USD$139.23
Price when purchased online
- Free 30-day returns
How do you want your item?
Columbus, 43215
Arrives between Apr 7 - Apr 9
|Shipping fee $5.98
Sold and shipped by Best Prices & Service
4.376146788990826 stars out of 5, based on 218 seller reviews(4.4)
Free 30-day returns
About this item
Customer ratings & reviews
0 ratings|0 reviews
This item does not have any reviews yet
Related pages
- Brand: General Procurement
- Cisco Press
- Powershell Scripting Basics
- Cisco Lab
- Cloud Service Model
- Federal Aviation Administration (faa)/aviation Supplies & Academics (asa)
- General Hardware Books
- Peripherals Books
- Cybernetics Books
- General Data Transmission Systems Books
- Trade & Tariffs in International Relations Books
- General System Administration Books